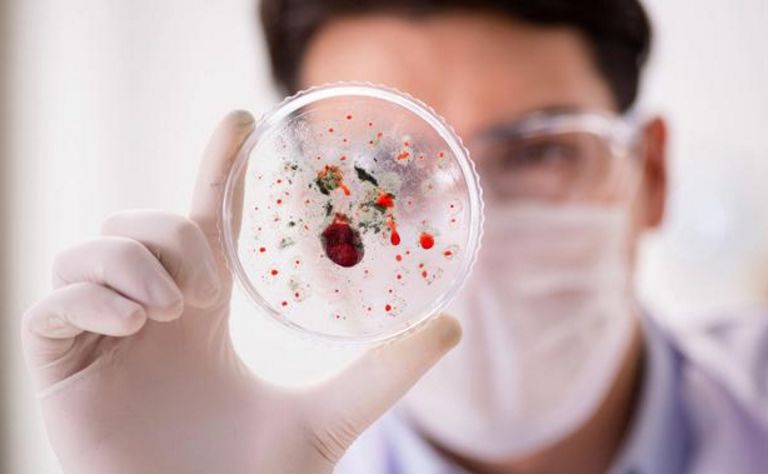

月经,很多女人叫它"大姨妈",对于这个"亲戚",很多女人是又爱又恨啊。
其实,月经不只是维持女人美丽的源泉,也是女人身体健康的"晴雨表"。
尤其是一些妇科疾病中,月经是最明显的病变信号!

32岁的小丽(化名),最近一直月经不调,先是月经淋漓不净,有时候月经明明走了,还总是见红,后来越来越严重,一个月竟然先后来了三次月经,算下来就没干净几天。
这哪受得了啊,小丽赶紧去了医院,检查结果却让小丽难以接受,医生说小丽已经得了宫颈癌,而且已经到了晚期。

躺在病床上的小丽一直不能平静,哭个不停,口口声声说,这是报应,都是报应。
这到底是怎么回事呢?
事情还要从十年前说起,小丽当时刚毕业就和同班同学小伟结婚了,婚后头三年还挺好,后来小丽生了儿子,辞了工作在家,小伟为了照顾家里生活,每天早出晚归工作。

这样又过了三年,小丽的儿子上了幼儿园,小丽赋闲在家才感觉到寂寞,每天给小伟发信息,小伟忙工作也总是不回,这让两个人的感情越来越淡。
就在这个时候,小丽在健身房结识了做健身教练的小刚,小刚很会说话,哄女人开心,一来二去,两个人就好上了。

小伟发现后,甚至没有埋怨小丽,只是要求小丽断了来往,好好过日子,可小丽非但没有答应,还坚决要离婚,之后如愿和小刚再婚。
算起来,小丽和小刚也结婚三年多了,早已没了当初的热情,婚后小丽也发现,小刚不是个长情的人,经常在外面偷腥,两个月前,小丽还在自己家里抓了现行,不得已又离婚了。
小丽本来以为这就是自己的报应了,没想到这报应还没完,现在自己还罹患了宫颈癌。
得知事情经过,医生也说,小丽的这个后来的丈夫算是一个"高危丈夫",小丽之所以早早患上宫颈癌,这个高危丈夫是"祸根"。
现已证实,男性因素在宫颈癌的发生也占有一定比例,凡有"高危丈夫"的妇女,容易患宫颈癌,"高危丈夫"是指以下情况:
(1)有多个伴侣者:这还用说么,这种传播疾病的几率自然是高了;
(2)包皮过长者:这类人的妻子患宫颈癌的机会也明显增加;
(3)前一任妻子患宫颈癌:如果丈夫的前一任患有宫颈癌,那么后一任患宫颈癌的危险性,比前一任要高出3.5-4倍。
宫颈癌是女性,尤其是已婚已育的女性中,比较常见的一种妇科疾病,也是一种难以治愈的癌症。宫颈癌最初的表现不是特别明显,但也并非无迹可寻。

出现3个异常表现,小心宫颈癌,抓紧就医
表现一:白带异常
宫颈癌最开始的表现是白带异常。色黄,白带清澈如水,有一股臭味。
表现二:月经异常
非经期出血,也可表现为接触性出血,早期出血量少,晚期病灶较大表现为大量出血。
表现三:排便异常
宫颈和肠道位置临近,当肿瘤在宫颈内长大,可压迫肠道,导致排便腹痛、长期便秘等异常。

养护子宫,预防癌变,做好这几点:
1、积极对抗妇科炎症
慢性炎症,与细胞癌变,有协同致癌作用。
女性一定要注意,积极预防改善妇科炎症。
女性对抗炎症,不要滥用抗生素,以免产生抗药性。
可以用一些消炎杀菌的小植物,泡水代茶饮,是不错的选择。
黄谷丁洛神花茶,泡水喝,消炎杀菌,对抗炎症,抗氧化,十分有益。

黄谷丁,是一种常见的“药食两用”的小植物,有着“天然抗生素”之称,它在一定程度上可以代替抗生素,对于预防改善妇科炎症,十分有益。
并且,黄谷丁还有“尿床草”的美誉,可利尿通淋,通过尿液的冲刷,对尿道炎、尿路感染、盆腔炎有治疗作用。
洛神花含有大量的花青素,可清除自由基、抗氧化、抗衰老,亦可利尿排石,对于女性健康,十分有益。
经常用这两者,搭配在一起,泡水喝,对抗炎症的同时,还可抗氧化、促排毒,是女性健康不错的选择。

2、适当运动,强免疫
免疫力,是抵抗疾病的“盾牌”。
免疫功能低,人们更易受到各种病毒或者细菌的感染,从而导致宫颈部位发生病变。
适当的运动,可以增强免疫力,提高女性对抗病毒的能力。
此外,如果缺乏运动,则会增加罹患宫颈癌的风险。
建议每周至少保持30分钟的有氧运动,能大幅降低患子宫颈癌的风险。

适度的有氧运动,能使子宫血液循环加快,还能对腹部脂肪进行燃烧,有利于子宫保养。
在所有的有氧运动中,快走,是最实用的运动,这种运动方式,不但能直接刺激子宫,还能带动腹部脂肪,有效保护子宫。

练瑜伽,能在健身的同时,调理子宫,坚持进行瑜伽锻炼,有助于扩展胸部,按摩腹部器官,促进体内气血平衡,加速血液循环,从而达到养护子宫的目的。

游泳,可促进新陈代谢,还能提高子宫的收缩力,使子宫内的温度得到提升。
坚持每周游泳2个小时,对子宫保持年轻化有很大帮助。

3、注意个人卫生
女性的生理结构比较复杂,一定要注意个人卫生。
女性要每天更换内裤,并且,在用纸擦拭的时候,建议可以从前向后擦拭,可以避免细菌侵入,出现炎症。
平时清洗的时候,要选择温水,不要轻易的用一些肥皂或者是洗液,否则可能会影响酸碱平衡,反而更容易让有害细菌滋生。
此外,经期要避免同房。

4、定期筛查
宫颈癌与其它疾病不同,发病非常迅速,发展也极快。
因此,建议女性朋友们,及时的进行筛查,防患于未然。
定期到医院做抹片检查,绝对是最重要的一项工作。
千万不要因为害羞,或者是其他原因而忽略。

图片来源网络,如有侵权,麻烦联系删除,谢谢!